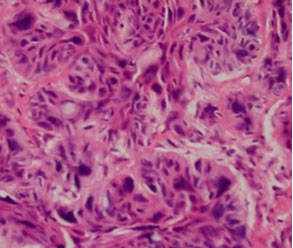

Neoplastic Dermatology
Dermatopathology Benign Tumors
Angiofibroma - see Soft Tissue
Keratoacanthoma
Bowen's disease
Clear cell acanthoma
Cylindroma
Dermatofibroma - see Soft Tissue
Bronchogenic cyst
Epidermoid cyst
Ganglion cyst - see Bone and Joint
Glomus tumor - see Soft Tissue
Hemangioma (Capillary hemangioma, Cavernous hemangioma, Pyogenic granuloma) - see Soft Tissue
Epithelioid hemangioma - see Blood Vessels
Kaposi sarcoma - see Vascular Path
Keloids and scars
Lymphomatoid papulosis (LyP)
Neurofibroma - see Nervous System Tumors
Piloleiomyoma
Sclerotic fibroma
Seborrheic keratosis
Spiradenoma
Traumatic neuroma
Trichoblastoma
- (Cutaneous) Lymphadenoma
Trichodiscoma / fibrofolliculoma
Trichoepithelioma
- Desmoplastic trichoepithelioma
Trichilemmoma
Trichilemmal (Pilar) cyst
Venous lake - see Vascular Path
Sebaceous adenoma
Melanocytic Lesions
Ephelis (freckle)
Albinism
Vitiligo
Melasma
Architecturally Disordered Nevus
Atypical Lentiginous Nevi
Becker nevus
Blue nevus
Congenital Melanocytic Nevi
Deep Penetrating Nevus (DPN)
Dysplastic Nevus
Halo nevus
Junctional nevus
Nevocellular nevus
Spitz nevus
Recurrent (persistent) nevus
Nevi of "special sites"
Atypical Genital Nevi
Melanoma In Situ on Sun-damaged Skin (Lentigo maligna)
Lentigo maligna melanoma
Melanoma (general)
- Desmoplastic Melanoma
- Lentiginous Melanoma
- Nevoid Melanoma
- Nodular Melanoma
- Superficial Spreading (Pagetoid) Melanoma
- Acral melanoma
- Acral lentiginous melanoma
- Spitz Melanoma and Spitzoid Melanoma
- Metastatic Melanoma
Idiopathic Guttate Hypomelanosis (IGH)
Dermatopathology Cancers / Tumors
Actinic keratosis
Cutaneous metastasis
Adenoid cystic carcinoma
Atypical Fibroxanthoma (AFX) - see Soft Tissue
Dermatofibrosarcoma Protuberans (DFSP)
Neurofibroma
Pilomatrixoma
- Malignant pilomatrixoma (pilomatrix carcinoma)
Eccrine Poroma
- Malignant Eccrine Poroma (Porocarcinoma)
Basal cell carcinoma (BCC)
- Morpheaform BCC
Squamous cell carcinoma
- SCC of Penis
Epithelioid histiocytoma
Epithelioid hemangioma
Granular cell tumor - see Soft Tissue
Merkel cell carcinoma
Mycosis fungoides - see Lymphoid neoplasms
Nerve sheath myxoma (Neurothekoma) - see Soft Tissue
(extramammary) Paget's disease
Post-Traumatic Melanocytic Proliferations
Proliferating scars
Syringoma
- Syringomatous carcinoma
Microcystic adnexal carcinoma (MAC)
Endocrine mucin producing sweat gland carcinoma (EMPSGC)
Pleomorphic Dermal Sarcoma (PDS)
Dermatopathology Benign Tumors
Acrochordon
- aka skin tag
Small, soft, common, b9 pedunculated lesion usually found on obese pts that can be skin-colored or hyperpigmented esp in skin creases such as the groin or armpit; perianal skin tags assoc c Crohn dz
- rarely, can be assoc c Birt-Hogg-Dube, acromegaly, and PCOS
Micro: fibrovascular core with fat and unremarkable epidermis
Tx: excision
Acrochordon (skin tag)

Keratoacanthoma
Could be derived from infundibular part of hair follicle, or possibly a subtype of well-diff SCC
- 4/5 Males, usually on face, which grows quickly over about 2 months, then spontaneously regresses (slowly) over 6 months, leaving a depressed scar behind
Gryzbowski type - lots of eruptive lesions
Ferguson-Smith type - lots of ulcerating tumors with atypical distribution
Micro (phases):
Early - well circumscribed solid lobules of large pale sq cells c little keratinization; mild atypia and distorted follicular infundubuum
Stable - central keratin plug but no granular layer;
- also larger and more atypical squamous nests and islands c lots of lichenoid inflam and eos but no plasma cells; possible neutros microabscesses
Regressing (resolving) - keratin filled crater, mature epithelium without atypia; flattening cup-shaped dermis
- not as much inflam as previous stage
IHC:
- negative p53 (mostly, mostly)
Genes: distinct from SCC 2/2 studies on telomerase, p53 and COX2
Keratoacanthoma

Bowen's disease
- aka SCCIS
Slightly raised erythematous plaque c irreg borders believed to be preneoplastic, but not found on sun exposed areas
- aka erythroplasia of Queyrat if on genitals or in mouth
Micro: clonal atypical skin cells found throughout epidermis - a full thickness "wind-blown" appearance
- inc (atypical) mits, intercellular bridges, can go into sweat glands
- apoptotic skin cells in nests
IHC: (+) p53, HMWK (CK903), HPV
Genes: aneuploidy

Bowen's disease
Clear cell acanthoma
- aka Degos acanthoma
although initially described as neoplastic, now seen as a reactive dermatosis
- usually is a moist solitary firm red-brown well-circumscribed nodule up to 2 cm or a plaque on the lower extremities of middle-aged to elderly pts
- grossly has a crusted, scaly peripheral collarette and vascular puncta on the surface and is characterized by slow growth and persistance for many years
Micro: sharply demarcated (abrupt) border with psoriasiform epidermal hyperplasia c thin parakeratosis over lesion c enlarged keratinocytes and basal cells c pale-staining glycogen rich cytoplasm, mild spongiosis and scattered neuts (which can form small microabscesses)
Clear cell acanthoma


Cylindroma
- aka turban tumor
Kinda common b9 adnexal tumor of head/neck that appears as papules or nodules as a slow-growing and usually solitary tumor that is generally painless; etiology is unknown; F>>M
- may be assoc c AD Brooke-Spiegler syndrome if multiple in the dz's facial trichoepithelioma and eccrine poroma
Gross: looks like brain gyri
Gene: CYLD gene mutations cr 16q12-13
Micro: islands of basaloid cells in jigsaw pattern c scant cytoplasm surrounded by thick pink hyaline membrane and hyaline droplets bwt islands
- 2 types of epithelial cells peripheral cell (large basophilic nucleus which palisades); pilar cell (centrally located c vesicular chromatin pattern)
Tx: simple surgical excision can be curative
Px: excellent
- rarely can transform to a malignant lesion

Cylindroma


Cylindroma
Dermatofibroma
Slow-growing painless nodules in extremities of adults
- see Soft Tissue for more details
Histo: spindled cells in storiform pattern that can wrap around collagen bundles
IHC: (+) CD68, SMA, factor XIIIa
- neg CD34
Bronchogenic cyst
See Lung
Epidermoid Cyst
- aka Epidermal Inclusion Cyst
Connects through the surface usually with a little hole (punctum) which may have neutro infiltrate if ruptures
- lining looks like surface epithelium but without adnexal structures and can have rete ridge pattern in young cyst that flattens out as pressure increases within the cyst
- can have loose lamellar keratin within the cyst wall
Pilnidal Cyst
Hemangioma (Capillary hemangioma, Cavernous hemangioma, Pyogenic granuloma) - see Soft Tissue
Kaposi sarcoma - see Vascular Path
Keloids and scars
Scars have an east to west orientation of fibroblasts with a north-south orientation of vessels
- elastic tissue gets lost and epidermis is effaced
Keloids ave broad, pink "bubble gum" bands of collagen
- abnormal rxn to injury, esp occurs in black peoples' earlobes
- Long, wide eosinophilic collagenous bands w/ fibro- and myofibroblasts [(+)- vimentin, actin, nonmuscle myosin, fibronectin] in bwt.; located in dermis
-- also see telangiectasias (dilated vessels near skin surface)


LyP type A

Lymphomatoid papulosis (LyP)
- a CD30-positive lymphophroliferative disorder
Rare, Indolent (self-healing) and chronic papulonodular skin dz c recurrent crops of pruritic papules at different stages of development that arises on the trunk and limbs; ~50 yo M, younger F
- histologically is a CD30+ proliferation of atypical T cells (is part of primary cutaneous CD30+ lymphoproliferatice disorders that includes Primary Cutaenous Anaplastic Large Cell Lymphoma [PC-ALCL] and borderline CD30+ lesions) - has many histologic mimics
- inc freq of prior, coexisting or subsequent lymphoproliferative disorders, usually mycosis fungoides or Hodgkin lymphoma
6 major subtypes:
Type A (MC, ~3/4): Hodgkin-like large atypical cells with intermixed mixed inflam infiltrates (neuts, lymphs, eos, histiocytes)
Type B: MF-like cerebriform cells c predominant epodermotrophic infiltrate
Type C: ALCL-like c large atypical cells and few other inflam cells (distinction from ALCL primarily clinical)
Type D: CD8+ cytotoxic T cell lymphoma-like c pagetoid infiltrate of epidermotrophic small to med-sized atypical CD8+ and CD30+ cells
Type E: Angiocentric infiltrates of small to med pleomorphic cells
Lyp with 6p23.3 rearrangement: Biphasic c small to med cerebriform cells and large atypical cells; usually seen in older adults
Micro: wedge-shaped infiltrate of T cells
IHC: (+) CD30 (CD30+ cells may be aberrant T cells) ,CD3 / 4
- neg ALK, CD8, CD56 (rare +)
DDx: Some immunoblasts, reactive T-cells, can be CD30+, scabies and arthropod bites can have a lot of CD30+ cells too
- Primary cutaneous anaplastic large cell lymphoma (PC-ALCL) can have lots of large ugly cells, the only way you would be able to differentiate is from IRF4 and the clinical history (if waxes and wanes, may consider LyP)
Dx: TCR rearrangement in 2/5 to 5/5 [1]
Px: excellent; although at inc risk secondary or nodal lymphoma such as MF, PC-ALCL and Hodkin lymphoma (up to 1/5)
- not known why there is spontaneous regression, but may be due to simultaneous expression of CD30 and CD95 (Fas) ligand
LyP - Scattered large cells with scattered smaller cells and neutrophils (mixed inflammatory background) wiht eos

LyP


LyP type C with diffuse sheets of CD30+ cells
Leukemia cutis
Usually reserved for AML or some other kind of nasty leukemia involving the skin, not for just some mature B-cell neoplasm involving the skin (would just say, eg, CLL/SLL involving the skin)
- histiocytes and monocytes like to go to the skin, so things like AMML like to go to the skin, and tend to have a more histiocytic appearance and to stain with CD4
- since the cells are more monocytic in the skin, tend to stain less with the markers that they would stain with in the bone marrow, such as CD117
Micro: sheets of malignant cells with reticular dermal collagen intact
If you see this and the clinicians do not know that the patient has leukemia (in the blood) you need to get a PBS immediately and see what is going on in the blood
- it is rare to have leukemia cutis without seeing PB involvement
Ddx: there is a variant of Sweet's syndrome (histiocytoid Sweet's syndrome) with left-shifted myeloid cells that can look like leukemia cutis, which also stains with MPO and may look like leukemic blasts
- may include CD3 and CD20, as well as TdT to cover lymphoblastic neoplasms
- BPDCN can also look similar, so may want to include CD56
Leukemia cutis- cells going through collagen bundles because leukemic cells are dyscohesive versus other malignancies

Subtle case of leukemia cutis around hair follicles

Piloleiomyoma
Multiple firm red-brown lesion in 3rd decade that are derived from arrector pili muscle and can be painful when exposed to cold
Reed's syndrome - AD fumarate hydratase gene mutation; may be related to papillary RCC or uterine leiomyomas if multiple
Micro: Pilo arrector muscle on roids c interlacing sm muscle and cigar-shaped nuclei and perinuclear vacuole
- circumscribed but non-encapsulated nodule
Piloleiomyoma


Sclerotic fibroma
May be clue for Cowden syndrome
"starry night" or "plywood" storiform pattern of collagen, hypocellular with bland nuclei
Sclerotic fibroma

Parakeratin in a horn pseudocyst in an inflamed sebk


irritated seb K


In an irritated Seborrheic keratosis melanin from trapped melanocytes can fall out of cells and get eaten up by very dark-appearing melanophages

Seb k, note the flat bottom
Seborrheic keratosis



Seborrheic keratosis
B9, common flat greasy pigmented "pasted on" lesion on trunk, head extremities on hair-bearing body parts of older pts ("senile warts")
- may clinically look like melanoma, or like SCC if irritated
Micro: has thickening of the epidermis with fat rete ridges that connect to each other filled with bland cells with pigment; cells usually have pigment in them, making them look dark grossly
- usually can draw a straight line at the bottom of the rete ridges (non-invasive, has flat bottom)
- horned pseudocysts ("pseudo" bc really connect to the surface) filled with loose orthokeratin (same kind as in the superficial epidermis) which connect to the surface, making them seem to grow like a lump from the skin
- if have keratin pearls (parakeratosis) may consider SCC, although can form pearls if inflamed
- if irritated can have inc mits
Dermatosis papulosa nigra = multiple lesions in younger black pts
Leser-Trelat sign = rapid growth of multiple seb k's; assoc c internal malignancy (GI or lymphoid)
Micro: Acanthoma c "shredded wheat" stratum corneum, epidermal acanthosis, papillomatosis, hyperkeratosis, horn pseudocysts
- flat uniform base without significant atypia
- variety of subtypes: acanthotic, hyperkeratotic, reticulated, clonal
Subtypes:
Acanthotic - MC variant, thick layer of basal cells c horn cysts and pseudohorn cysts [keratin grows downward into mass], lamellar hyperkeratosis, papillomatosis
Clonal - islands of bland uniform ("clones") skin cells in epidermis
Pigmented - has small pigmented skin cells
Irritated - sq metaplasia c spindly look and red cytoplasm and swirling sqamous cell eddies c atypia and mits, looks like ca
- look for horn cysts
Inflamed - spongiosis and lymphocytes
- can have lichenoid inflam and grow a crust
Hyperkeratotic - lamellar ("shredded wheat") keratin c papillomatosis (tall corneum layer ["church spires"])
Reticulated - net-like appearance of pigmented cells, (+) horn cysts
Genes: can produce extra BCL-2
- Fibroblast Growth Factor Receptor 3 (FGFR-3)
Tx: excision
Seborrheic keratosis with flat bottom and heavy lichenoid inflammation
Spiradenoma
Usually presents as solitary, violaceous, gray-blue nodule that tends to arise on the ventral aspect of the head, neck, trunk, and sometimes extremities
- usually young adults (15-35 yo), can be painful
May be found in Brooke-Spiegler syndrome (cylindromas, spiradenomas, trichoepitheliomas)
Closely related to cylindroma (may occur as a hybrid tumor), those these are usually sporadic whereas cylindromas are multiple and inherited
- spiradenomas may present as a tender nodule
Micro: Large ball of dark blue cells (cannonballs) that are not attached to the epidermis tc interspersed black lymphs and paler cells in the middle of the ball c dark red droplets of hyaline
DDx: considered sometimes to be on a spectrum with cylindroma


Spiradenoma
Spiradenoma

Nevus Sebaceus
- aka nevus sebaceus of Jadassohn or organoid nevus
Present at birth, found on the head, and neck/scalp
- rarely assoc c seizures, mental retardation or visual problems
- several adnexal and epithelial tumors known to grow within nevus sebaceus, such as BCC, Trichilemmoma, proliferating pilar tumor, syringocystadenoma papilliferum, trichoblastomas, and more
Gross: tan-brown, alopecia, rough surface; becomes verrucoid during puberty
Micro: acanthosis and papillomatosis, inc sebaceous glands, which are found abnormally high in the dermis
- hair follicles usually vellus rather than terminal, and are reduced in number
- dilated apoeccrine glands



Nevus sebaceus of Jadassohn
SCAP (darker blue at bottom middle) growing in background of nevus sebaceus

SCAP


SCAP
Syringocystadenoma Papilliferum (SCAP)
aka papillary syringadenoma
b9 sweat gland proliferation that arises in the middle of a nevus sebaceus
- warty tumor of scalp, neck, and face that can occur at any age
- clinically is a slow growing or recent change in a brithmark, may be crusty and start to bleed
- 1/3 have adjacent nevus sebaceus, 10% with adjacent BCC
- malignant counterpart is syringocystadenocarcinoma papilliferum
Micro: glandular papillary prolif connected to skin surface
- has ducts that look similar to sweat ducts sometimes, which are lined by cuboidal cells, that eventually empty to skin surface
- dense plasma cell infiltrate in the dermis, or in the middle of the papillary structures
Traumatic neuroma
Prolif changes due to trauma or even burns or bites
Histo: well-defined but non-encapsulated mass of axons and Schwann cells in scar tissue next to a damaged nerve
Trichoblastoma
An adnexal tumor made of ribbons of basaloid cells with basaloid islands, clefts bwt collagen, concentric fibroblastic rich stroma with no retraction
Micro: cells can look a lot like BCC, but the stroma has concentric fibroblast-rich collagen
- papillary mesenchymal bodies can be in the stroma, but mucin will never be in stroma (mucin only within tumor islands)
Trichoblastoma



Lymphadenoma
- aka adamantinoid trichoblastoma
Variant of trichoblastoma with blue tumor islands that have up to 2 layers of peripheral basal cells
- center of the islands are pale due to clear cells and inflammatory cells (lymphocytes and histiocytes)
- fibroblast-rich stroma with no retraction
Tx/Px: B9, just needs F/U

Cutaneous lymphadenoma
Trichodiscoma / fibrofolliculoma
- Birt-Hogg-Dube syndrome may not be real bc acrochordons may just be on the spectrum of trichodiscoma / fibrofolliculoma (???)
Spectrum from fibrofolliculoma to trichodiscoma
Fibrofolliculoma: has cords or strands of epithelial cells, 2-4 cells thick radiating from follicular structures which may have keratin
Trichodiscoma: well-circumscribed but not encapsulated tumor;
- may have folliculosebaveous collarette resembling fibrofolliculoma
- fascicles of loose finely fibrillar CT c intervening mucous
Trichodiscoma in Birt-Hogg-Dube

Trichodiscoma

Trichoepithelioma
A type of trichoblastoma, also with basal cell appearance (basaloid cells c peripheral paslisading), concentric fibroblast-rich stroma, mucin only in tumor islands (not stroma), papillary mesenchymal bodies (PMB)
- multiple familial trichoepitheliomas (epithelioma adenoides cysticum) may have AD inheritance, CYLD (cylindromatosis) gene on cr 16q12-q13
- present as several small skin-colored papules in nasolabial folds
Brooke-Spiegler syndrome - numerous trichoepitheliomas and cylindromas
Rombo syndrome - trichoepitheliomas, milia, hypertrichosis, BCC, atrophoderma, vasodilation and cyanosis
Micro: May see horn cysts, calcifications, clefts bwt onion-skin collagen fibers in stroma
- finger-like projections with Swiss-cheese cribriform nodules
- stroma has the appearance of normal fibrous sheath of hair follicle (stroma is more cellular than in BCC)
IHC: (+) CD34 (in stroma), BCL-2 (at periphery of islands), CK20 Merkel cells (in tumor islands), BCC stains Ber-Ep4 diffusely
- PHLDA1 positive in BCC and not tricoeps
Trichoepithelioma


Desmoplastic trichoepithelioma
Presents as a firm donut on the cheeks of younger females with a central umbilicated nodule (dell)
Micro: tadpole-shaped islands (paisley-tie) c eosinophilic desmoplastic stroma
- calcifications and horn cysts common
- clefting only seen within stroma
- lymph aggs, apoptotic bodies and mits are rare
- no retraction space
- papillary mesenchymal bodies
IHC: scattered CK20+ Merkel cells
- not as many CK20+ cells as in Merkel cell carcinoma
Desmoplastic trichoepithelioma



Trichofolliculoma
One to several dilated follicles that have numerous radiating small follicles of varying degrees of maturity
- looks like mamma follicle is having baby follicles
small papule usually on the face of an adult
- a trichofolliculoma without hair is a fibrofolliculoma

Trichofolliculoma

Trichofolliculoma
Trichilemmoma
Small, solitary asx papular lesion seen almost always on the face
- arises from trichilemmal part of follicle (c clear glycogenated cells)
Micro: differentiate toward outer root sheath
- sharply circumscribed, c lobules extending to upper dermis and in continuity with the epidermis or follicular epithelium
Some think is a form of a wart involving a hair follicle, or maybe a b9 follicular tumor
Basically is warty surface with hair follicle bottom
Look like the glycogenated outer root sheath of normal hair follicle
- can form cutaneous horns, which can also be seen in warts, SCC, actinic keratosis
- assoc c Cowden syndrome (PTEN gene) if multiple, aka PTEN hamartoma tumor syndrome (visceral hamartomas, thyroid adenomas, ovarian cysts, subcutaneous lipomas and neuromas, GI polyps, carcinomas of the breast and thyroid)
Pale lobules made of clear glycogenated cells (glycogen washed during processing) attached to epidermis c peripheral palisading and outlined by thick glassy red "vitreous" BM
DDx: SCC (must have atypia to dx SCC)
Trichilemmoma forming a cutaneous horn bottom part is large and pushing into dermis

Trichilemmoma - Papillomatosis with overlying parakeratosis and some orthokeratosis (without nuclei); also seen in warts


Trichilemmoma - blood and serum in the keratosis (can also be seen in warts)

Trichilemmoma - base of lesion has palisading outside layer of cells next to clear glycogenated cells, like a hair follicle
Trichilemmal (pilar) cyst
2nd MCC epidermal cyst (after inclusion), mostly on scalp of women
- may have AD inheritance
Histo: lined by stratified squamous epithelium w/o inner granular layer and abrupt keratinization (like the trichilemma of the outer root sheath of a hair follicle)
- made of hard keratinaceous material that can have calcifications
Trichilemmal (pilar) cyst


Pilonidal Cyst
Skin infx that occurs bwt cheeks of buttocks, usually at the top of the crack, with pain, swelling, and redness, and can have drainage of fluid
- risk factors include obesity, fam hx, prolonged sitting, greater amts of hair, and not enough exercise
- believed to be a mechanical process
DDx: can resemble a dermoid cyst, or a sacrococcygeal teratoma
Tx: I&D
- may prevent recurrence by shaving the area
Pilonidal cyst

Inverted follicular keratosis
Centered on hair follicles
b9; can get reactive atypia and are usually transected on biopsy
- may tell clinician to keep an eye on it and rebiopsy if grows back, or to just re-excise if has enough atypia
Micro: keratinocytes making "squamous eddies" (also seen in irritated seb K)
- bottom of lesion is bulb-shaped and pushing into dermis
-- may get confused with squamous pearls of SCC, although here the squamous eddies are found in the middle of the lesion, and in SCC the squamous pearls are usually invasive into the dermis
Inverted follicular keratosis with squamous eddies
Inverted follicular keratosis centered on hair follicle, surrounded by squamous eddies


Tumor of the Follicular Infundibulum
Subepidermal tumor made of reticulared cords and nests of pale or pink glycogen-containing cells
- looks likes cells are falling off the epidermis
Tumor of the Follicular Infundibulum

Milia
aka mild spot or oil seed, is a clogging of the eccrine sweat gland, keratin-filled cyst that appears just under epidermis or on roof of mouth
- usually assoc c newborn babies, but can appear at any age
-- sometimes can be confused with STDs or stubborn whiteheads
Tx: usually disappear within a month in newborns, may be excised in adults
Milium


Proliferating Pilar Cyst
Micro: well-circumscribed mass of eosinophilic squamous epithelium that forms multiple small cystic structures that keratinize abruptly to dense eosinophilic trichilemmal keratin
DDx: SCC (lacks circumscription and has cytologic atypia)
- keratoacanthoma (made of eosinophilic epithelium, but also has crater-like architecture and is not as well-circumscribed)
- pilar sheath acantoma (proliferation of bland follicular epithelium that radiates from a central dilated follicular structure)
Image reference: http://ispub.com/IJD/4/2/7225

Proliferating Pilar Cyst

Trichoadenoma

Proliferating Pilar Tumor

Dermatopathology Cancers / Tumors
Actinic keratosis (AK)
UV-light induced
Premalignant lesion to SCC caused by sun exposure
- risk of carcinoma proportional to epithelial dysplasia
- small, rough, erythematous or brownish papules
Keratinocyte dysplasia caused by UV light exposure
- also see parakeratosis, basal keratinocyte atypia (enlarged and crowded), with parakeratosis and solar elastosis
- aka solar or senile keratosis, actinic cheilitis on lips
Variants:
Acantholytic - clefts c rounded cells, usually pigmented
Atrophic -skin only up to 4 layers deep
Bowenoid -atypia throughout the thickness
Hyperkeratotic -has cutaneous horns
Pigmented - looks like solar lentigo, not atypical but has downward projections
- increased pigmentation in basal layer, but no atypia or significant inc in melanocytes
Micro: basal cells and squamous atypia c hyper- and parakeratosis and disordered maturation; parakeratosis and solar elastosis heavy
- no granular layer (except at follicular orifices)
- cornified layer has pattern that alternates bwt compact orthokeratosis and normal orthokeratosis that overlies and spares the follicular infundibulum
- can be found c melanocytic atypia
- broad-based budding
Tx: excision, possibly topical chemo


AK - atrophic form


AK

Bowenoid AK

AK
Actinic keratosis - cutaneous horn


AK
Cutaneous Metastasis
MCC cutaneous mets are adenocarcinomatous deposits
- more specifically, from breast ca (23%; MCC in females), then lung (MCC in males) and colorectal
"Penny stacked up" look of breast ca mets from tumor cells lined up bwt collagen
MC site for skin to met to is the chest/abd, then head and neck
Adenoid cystic carcinoma
May be primary or met
- primaries are less aggressive than systemic types
Histo: tumor cell islands, possibly cribriform in fibrous / mucinous stroma, thick hyaline membranes
IHC: (+) HMWK / LMWK, S100, CEA
Px: Local recurrence in 50%
- likes to invade perineural spaces
Atypical Fibroxanthoma (AFX)
see Soft Tissue
weeee*** SLAM - spindly dermal lesions abutting epidermis ***
Spindled SCC, Leiomyosarcoma, AFX, Melanoma
Dermatofibrosarcoma Protuberans (DFSP)
**it's Dat Fat Suckin Prick *** (neurofibromas and dermatofibromas can also have fat entrapment)
- aka intermediate (borderline) fibrous histiocytoma
Low to int grade slow-growing, locally aggressive cancer MC in trunk (never the hands/feet) of 3rd to 5th decade blacks
- may derive from nerve sheath tumor of dermal dendritic cells
- can progress to fibrosarcoma of MFH
- strong storiform pattern of monomorphic fibroblastoid cells that invade subcutis
- variants include pigmented DFSP (Bednar tumor), myxoid DFSP, DFSP with myoid differentiation, plaquelike DFSP, giant cell fibroblastoma and fibrosarcomatous DFSP
Gross: Nodular, polypod, plaqoid, avg 5 cm, gray-white; rarely bleeding or necrosis
Micro: uncircumscribed, hypercellular, prominent storiforming (can be absent early on in plaque phase) that infiltrated deep to subQ and entraps fat cells in honeycomb pattern
- cancer cells are monomorphic c little red cytoplasm and dark nuclei (like a neurofibroma) - translocation sarcomas look pretty monotonous
- can have lots of mits (which are not atypical)
IHC: (+) CD34, vimentin, actin, ApoD, bcl2, CD99
- negative Factor XIIIa, D2-40, keratin, EMA, S100, HMB45, desmin, CD117
- can lose CD34 with fibrosarcomatous transformation!
Genes: t(17,22)(q21;q13) collagen type 1 alpha 1 gene and PDGF-Beta chain gene (COL1A1 and PDGFRB) in nearly every case
Tx: exicision c underlying fat
- imatinib if inoperable or recurrent
Px: 10-15% have fibrosarcomatous transformation where the tumor exhibits high-grade morphology and loss of CD34 expression, while maintaining the signature COLIA1-PDGFB fusion gene
-- these fibrosarcomatous DFSPs have a similar local recurrence, but 13% develop distant mets
- the ddx of fibrosarcomatous transformation of DFSP is spindle cell melanoma and the rare cutaneous MPNST
DFSP


Pilomatrixoma



Pilomatrixoma

Trichohyaline granule (which are usually seen in hair shafts) in a pilomatrixoma
Pilomatrixoma
- aka calcifying epithelioma of Malherbe
solitary, bluish, firm (often calcifies), benign subepidermal spherical nodule
b9 hair follicle tumor
MC on face of kids or young adults
- 75% of childhood adnexal tumors
- can have multiple lesions in myotonic dystrophy
Sharply circumscribed cyst-like structure in dermis, possibly contiguous with hair follicle (may arise from hair matrix)
- can have inc mits (the malignant form is rare and usually very atypical)
- may have trichohyaline granules (which are usually seen in hair shafts)
3 cell types in fragmented cyst wall:
1) outer layer of blue (basophilic) basaloid martical cells with round nuclei and scant cytoplasm which dies and become dead keratin, which are the ghost cells
- imitate the cells in the root, or bulb of a normal hair follicle
2) mixed zone of eosinophilic cells c large round vesiculated nuclei
3) central zone sheets of keratinized pink "ghost" or "shadow" cells c distinct cell borders and central unstained nuclei
- difference from BCC: basaloid cells undergo abrupt keratinization and form "ghost" cells
Has foci of foreign body reaction, calcifications and ossification in shadow cell lobules
See melanin in shadow cells
Fibrotic stroma infiltrated with granulomatous inflam
Solid nests of basaloid cells may cause misdiagnosis of BCC
Ddx: Basal cell carcinoma c matrical differentiation (differs by continuity with epidermis and abrupt transition into shadow cells without the eosinophilic zone)
Malignant pilomatrixoma (pilomatrix carcinoma)
Has cytologic atypia, infiltrating borders, transitions to squamous cells, clear cells, mitosis and necrosis
- can have sarcomatoid features
Local recurrence common, and can metastasize
Eccrine poroma




Eccrine poroma
Eccrine Poroma
Friable papule/plaque MC on sole/scalp surrounded by indented moat (demarcation); resembles pyogenic granuloma clinically
- or is it found on extremities of middle aged adults??
Micro: monotonous cuboidal/basaloid "poroid" tumor cells in lower part of acanthotic dermis has a broad base that extends into dermis
- sharp demarcation (moat) between normal skin and tumor
- tumor cells may have cytoplasmic clearing due to glycogen accumulation; can also have melanin
- can see small sweat ducts in tumor (vs seb k)
Variations: 1) Hydroacanthoma simplex, 2) Syringofibroadenomatosis, 3) Sebocrine adenoma
1) Basaloid/clear cell clone prolif. w/ lumen of ducts entirely w/in epidermis (like Borst_Jadassohn intraepidermal epithelioma
2) Uncommon, reticular prolif of ducts in dermis that connects to surface ( like fibroepithelioma w/ sweat ducts); may be from Schoepf syndrome
3) Sebaceous + apocrine diff in poroma-ish lesion
IHC: EMA (highlights luminal component of the ducts)
DDx
1) Porocarcinoma (Malig eccrine poroma): rare, larger, more cytologic atypia/necrosis/ invasion; looks like SCC w/ sweat ducts
2) Nodular hidradenoma: looks a lot like eccrine poroma, but w/o the surface connection; but the "poroid cells" look identical
3) Seborrheic keratosis: the basaloid cells may look poroid; but you don't see any sweat ducts

Poroma
Malignant Eccrine Poroma (Porocarcinoma)
Tends to occur in the lower extremities, may occur as single or multiple (rare) skin lesions. Can arise from eccrine poroma, which is seen in the malignant form next to the cancerous cells. Can spread to dermis, but usually in dermis. 66% fatal due to mets. Name of the tumor has been used to refer to moderately differentiated adenocarcinoma. Invades through lymphatics.
Features:
- acanthosis in epidermis with tumor nests filled with cystic lumina
- asymmetric tumors
-cribriforming
-nuclear atypia with mitoses and necrosis
- spiraling ductular structures
- ducts lined by cuticular material
- zones of cytoplasmic glycogenation
- aggregated intraepidermal cells centered around acrosyringeal pores
-may resemble well-differentiated squamous cell ca.
-think mets with PAS-+ cuticle and ductular differentiation
- clonal ("intraepithelial epithelioma") pattern of acrosyringeal cells which may invade
-"pagetoid pattern" in mets
- &large lobules accompanied by prominent hyalinization and cyst formation with accumulation of amorphous eosinophilic material

Eccrine porocarcinoma
Acrospiroma
Dermal neoplasms, some believe related to or same as poroma)
- solid / cystic (nodular) hidradenoma, clear cell hidradenoma
- arise from seat gland distal excretory duct, usually solitary, on the scalp or axilla
- is a wastebasket term for these types of tumors
Gross: nodules c cystic foci high in dermis
Micro: nests or lobules of cells that look like an eccrine poroma c clear cytoplasm or distinct squamous metaplasia
- may show inc vascularity, and have lumens lined c coboidal ductal cells or columnar secretory cells
- cystic spaces may be 2/2 tumor cell degeneration

Acrospiroma
Hidradenoma
Uniform bland cells and ducts
Hidradenoma


Hidradenocarcinoma
rare, aggressive skin adnexal tumors of sweat gland origin that demonstrate a high potential for local recurrence, metastasis, and poor outcome
- no molecular markers for pathogenesis
http://www.archivesofpathology.org/doi/full/10.1043/1543-2165-134.5.781?code=coap-site

Hidradenocarcinoma

Pyogenic granuloma
Rapidly growing, sometimes painful, polypoid red mass that usually grows near fingernails or lips
Histo: Clusters / glomeruloid nests of vessels separated by hyphae that can look like hemangioma
- lacks atypia
IHC: mits can be prominent


Pyogenic granuloma

Nodular BCC with nesting, clefting and pallisading



Squamous differentiation in BCC
Superficial pattern BCC

Morpheaform / sclerosing / infiltrative BCC

Subtle, invasive BCC

Infiltrative BCC

Pigmented BCC
Adenoid BCC

Fibroepithelioma of Pinkus - just another for of BCC, should treat as such
Atypia in BCC- no need to worry


Granular cell variant of BCC
Clear cell variant of BCC

Amyloid in BCC - an normal finding, the pt has not systemic amyloidosis
Basal cell carcinoma (BCC)
NON-lethal skin cancer; locally invasive but almost never mets
- MC of ALL cancers
- MC in skin exposed areas of body
~ 90% bwt hairline and upper lip
~ 5% recurrence
- can look like dermatitis clinically or actinic keratosis
Rolled edges w central ulceration
- pearly papules w telangiectasias; palisading nuclei
~ form thymidine dimers due to sun exposure
3 criteria for dx: palisading, clefting and nesting
- myxoid change around edge of tumor, that can cause clefting artifact
- "Basal cells stroma" - changes with dilated vessels, lymphocytes and mucin around BCC
- irritated BCCs can get squamoid differentiation, probably do not need to mention unless is very diffuse
- infiltrating / sclerosing / morpheaform (all the same) may be more locally aggressive form of BCC, that may need to be more aggressively treated, can have perineural invasion if infiltrates really deep, and have higher rates of recurrence
- fibroepithelioma of Pinkus is probably just a form of BCC and should be treated as such
- can have areas of pleomorphism in BCC, if it merges into more normal looking BCC, probably do not need to worry or treat differently
- BCC can also blend into a part of the tumor that has large zones with fluffy granular cells that is called "granular cell variant of BCC" which usually transitions into areas of more normal looking BCC - can look like melanoma
- also can have clear ceell variant of BCC that should also transition into more normal looking BCC
- amyloid in BCC is probably just a breakdown product of degenerative keratin and does not mean that the pt has systemic amyloidosis (can be seen in other adnexal tumors
- may have stromal retraction around tumor
BCC can be pigmented and look like melanoma clinically
IHC: (+) CD34 (may be negative), BCL-2 (strong and diffuse)
- negative CK20+ Merkel cells (negative at least in tumor islands)
Tx: Moh's micrographic surgery
- if BCC is superficial pattern, dermatologist may choose to treat with topical agents
Morpheaform / Sclerosing / Infiltrative BCC
Present as scar-like lesions in older patients that expand and have ill-defined borders
- infiltrating / sclerosing / morpheaform (all the same) may be more locally aggressive form of BCC, that may need to be more aggressively treated, can have perineural invasion if infiltrates really deep, and have higher rates of recurrence
Micro: Thin tadpole-like (paisley tie) blue islands infiltrating sclerotic red stroma
- can have horn cysts (rare), but no ducts (clefts can be seen bwt epithliums and stroma)
- invasive islands can look like tadpoles (similar to MAC, see below)
- little to no mucin in stroma
- retraction space is often absent
Should make note on the report that it is this type of tumor because may be missed and recur during Mohs surgery
Squamous cell carcinoma
Very common; assoc w sun exposure on extremities
- usually appear on hands and face as ulcerative red lesions
~ assoc w chronic draining sinuses
Histo: can be crater or volcano or cupped shaped and filled with keratin, may be mistaken for a cyst
- keratin "squamous pearls", usually parakeratosis (with nuclei [vs orthokeratosis]) means that since nuclei retained it may be growing quickly
- glassy keratinocytes with lots of bright pink cytoplasm that push down to sun damaged skin
- be suspicious when you have a proliferation of keratinocytes with glassy cytoplasm in sun damaged skin
- the nuclei may not look very atypical toward the surface, so be careful if the biopsy is superficial
Locally invasive but usually no mets
- LNs are the MC site of mets for cutaneous SCC, and all pts c invasive cutaneous SCC should undergo regional LN palpation at the time of fx and during post-tx follow up (which can get FNA'd of excised if found to be larger than normal)
Actinic keratosis is a precursor lesion
SCC - kinda looks like a crater or volcano filled with keratin; do not mistake it for a cyst
Squamous pearl



More atypical cells towards the base of the SCC invading into the dermis
SCC of Penis
More common in 3rd world countries (>10%) carcinomas
- less common if circumcised at birth
- smegma as a cause?
- psoriatic pts tx'd w/UV inc risk 5x
- probable assoc w/ HPV
Glans > prepuce > coronal sulcus
Growth patterns: superficial, exophytic (fungating, verruciform), endophytic (infiltrating, ulcerating, vertical)
- micro types: usual, warty (condylomatous), verrucous , papillary
-- verrucous: Grade 1; extremely well differentiated throughout; 5% of all penis cancers; broad, bulbous expansions and lacks invasion
Penis cancer likes to spread; 15% nodal mets
- less common in exophytic types; more in endophytic
Recurrence rare if margins negative on resection
Stage most important prog. factor
- 77/71% 5/10 year prognosis, rahspect
- Probably will not be cured if 2+ nodes positive
Sarcomatoid (Spindle Cell) SCC
IHC: (+) vimentin
- pitfall, can be SMA (+)
*** SLAM - spindly dermal lesions abutting epidermis ***
Spindled SCC, Leiomyosarcoma, AFX, Melanoma
Epithelioid histiocytoma
Micro: sheets of polygonal cells that efface the dermis c nucleoli and mits
IHC: (+) CD163
- negative S100
Epithelioid hemangioma
- see Blood Vessels
- aka angiolymphoid hyperplasia with eosinophilia
MC in head/neck of 20-30 yo's
Histo: ill-defined lobulated intradermal lesion with lots of vessels surrounded by large endothelial cells
- not a lot of pleomorphism
- lots of inflam c lymphs, +eos and macros
Granular cell tumor
- see also Soft Tissue
Usually present on tongue but may appear anywhere, derived from Schwann cells
- cytoplasmic granules are phagolysosomes
Micro: Sheets of monomorphic large polygonal cells c lots of red granular cytoplasm and central nucleus
- pustulo-ovoid bodies of Milan - round red giant lysosomal granules
- caveat: may think of SCC 2/2 upper PEH
IHC: (+) S-100
Px: larger tumors usually do worse
- cannot predict behavior based on bland morphology

Merkel cell carcinoma


MCC
Merkel cell carcinoma (MCC)
- aka primary NE carcinoma of skin, trabecular carcinoma
Uncommon, aggressive cutaneous tumor that usually present on the head and neck of elderly pts in areas of sun damaged skin
- clinically are painless dermal nodules that are erythematous or violaceous (delayed dx since no sx)
- 80% of MCC are assoc c Merkel cell polyomavirus (MCPyV)
*** DDx for small round blue cell tumors in skin: blue LEMONS *** Lymphoma, Ewings sarcina, Merkel cell ca / melanoma, Oat cell ca of lung, Neuroblastoma, Small cell endrocrine carcinoma***
Micro: small round blue cells close together c little cytoplasm c molding, apoptotic cells and mits
- can have intraepidermal growth similar to melanoma
IHC: (+) synapto, chromogranin, NSE, CK20 (in dot-like perinuclear pattern), Neurofilament (8/8), AE1/AE3, Cam5.2, Merkel-cell polyomavirus
- neg: TTF-1
EM: membrane-bound dense core granules
Px: Worse if p63+; commonly recurs and mets, assoc c high mortality
More merkel cell ca

Mycosis fungoides - see Lymphoid neoplasms
MCC cutaneous T-cell lymphoma; MC in adult males
Histo: lichenoid rxn common; can see lymphocytic atypia
- Pautrier microabscesses: small intraepidermal lymphoid aggregates
IHC: (+) CD2,3,4
(Extramammary) Paget's disease
If found around breast can be 2/2 intraductal carcinoma, but if outside of breast MCC is de novo from pluripotent mammary glands along milk lines but may be an extension of an adenocarcinoma
Histo: pagetoid spread of neoplastic glandular elements in epidermis or mucosa
- rarely c underlying dermal involvement
- Intraepidermal prolif of large cells c lots of amphophilic cytoplasm, tumor cells c buckshot intraepidermal nests, crushed basal layer, atypical cells can spit out into corneum intact
IHC: (+) CK7, EMA, CEA, PAS (diastase resistant)
- negative S100, CK20
Extramammary Paget's disease

Post-traumatic Melanocytic Hyperplasia
Melanocytic hyperplasia is common around scars, in which melanocytes have clear cytoplasm and small dark nuclei but no atypia and don't really have lentiginous growth
- cytoplasmic processes usually well maintained in melanin stains
Proliferating Scars
Can look like desmoplastic malignant melanoma
- though this appears in site of previous injury (vs DMM [found on sun-exposed areas of head and neck in elderly])
Micro: bland fibroblasts that are aligned parallel to skin, lots of vessels
Syringoma
Present as small round nodules on the lower eyelids (usually)
- commonly assoc c Downs syndrome and Asian women
- probably derived from sweat gland ridge
- clear cell syringoma is assoc c DIABETES
Micro
Small tadpole-shaped (paisley-tie pattern) ducts c lots of pink cytoplasm in a densely sclerotic eosinophilic stroma
- tumor cells small and round
-may see some clear cells
- no infiltration, atypia, mits or local destruction
Eruptive syringoma
Found on chest / back / penis in young men and women, technically not neoplastic, is a reactive lesion of eccrine glands
- found on skin type VI (???)
Syringoma



Chondroid syringoma
- aka mixed tumor of the skin (?)
Morphologically identical to PA of salivary gland
Micro: exhibits structures such as glands/ducts, cysts, keratinous cysts, and foci of squamous differentiation, with a myxoid stroma typically having cartilagenous metaplasia
- inner luminal epithelial cells lack expression of ME markers
IHC: myoepithelial cells can co-express S100 and CK
DDx: MAC (syringoma has more eosinophilic stroma)

Chondroid syringoma

Chondroid syringoma
Syringomatous carcinoma
Islands in a desmoplastic stroma with keratinizing cystic structures and tubules
- diffusely infiltrates dermis
MAC


Microcystic adnexal carcinoma (MAC)
Present as plaques on upper lip, cheek or chin
* Distinguishing MAC from others (bcc morpheaform, desmoplastic trichoepithelioma, squamoid eccrine ductal ca, syringoma) requirest deep biopsy so the important features of MAC (deep tissue invasion and PNI) can be identified (from CAP VBP)
Biphasic c hairs and sweat ducts, also with the infiltrative tadpole glands, sclerotic stroma that can extend all the way to sk muscle
- poorly circumscribed
- perineural invasion common
- rarely have calcifications
- lymph aggs are common
- there is not much atypia
- look for perineural invasion to dx MAC (will not see in discoid trichoepithelioma)
Very similar in appearance to syringoma, desmoplastic trichepithelioma, eruptive syringomas, and morpheaform BCC, differential diagnosis is usually aided by clinical appearance
IHC: (+) CEA and EMA in ductal lumina
Px: locally aggresive, but indolent
DDx: disoid trichoepithelioma (cannot differentiate unless can see the wholes lesion, MAC can have perineural invasion which is not seen in discoid trichoepithelioma), BCC

The basic histologic pattern of MAC: variably sized ducts, nests, and cords of basaloid cells with clear-to-eosinophilic cytoplasm. The cellular differentiation of the outer root sheath of the hair follicular (trichilemmal) and many of the nests appear to recapitulate the structure of a primitive hair follicle

At least focal ductal differentiation required to dx MAC

Sebaceoma
- aka sebaeous epithlioma
More asymmetric and disorganized than sebaceous adenoma, but still well circumscribed
- +/- epidermal connection
- >50% basaloid cells (vs sebaceous adenoma [below])
- no atypia, but can have inc mits
DDx: BCC are positive for Ber-Ep4 but neg for EMA
- sebaceous tumors are strongly pos for D2-40 and EMA
- EMA stains mature sebocytes
- CK7 pos in basaloid cells
- oil red O (intracytoplasmic lipid contect)
- adipophilin - new protein

Sebaceoma
Sebaceous adenoma
Solitary or multiple, skin-colored, tan-yellow nodules, usually < 1 cm
- usually on the head and neck of older pts typically
- multiple lesions in younger pts (<50 yo) at extrafacial sites may be indicator of Muir-Torre syndrome (form of Lynch syndrome, AD, mutations in one of the DNA mismatch repair genes MLH1, MSH2, and MSH6, multiple sebaceous neoplasms and visceral neoplasms, unusually GI ca or keratoacanthomas of the skin)
the spectrum of sebaceous neoplasms includes 4 entities:
(b9) Sebaceous hyperplasia --> sebaceous adenoma --> sebaceoma ---> sebaceous carcinoma
>50% sebocytes; <50 basal cells (blue cells)
- b9, lobular growth (round base)
- non-infiltrating
- often eroded / ulcerated
Micro: Multilobular, several contiguous lobules c direct connection to epidermis / follicles
- central mature sebocytes dominate but there's an inc in peripheral basal cells (<50% basaloid cells)
- no cytologic atypia or abnormal mits
Cystic sebaceous adenomas are esp assoc c Muir-Torre syndrome
Sebaeous adenoma




Sebaceous adenoma


Sebaceous carcinoma


Sebaeous carcinoma
MC in eyelid (75%)
- meibomian gland MC (than Zeis)
- Upper eyelid > lower eyelid
- extraosseous seaceous CA (25%) worse px than ocular sebaceous ca
- less pagetoid spread
-rarely assoc c Muir-Torre syndrome, nevus sebaceous, rhinophyma
Micro: can be predominantly red (squamatized) or blue at low power
- atypia and mits common
- infiltrative border
- foamy cells c scalloped nuclei
- atypical cells can extend to epidermis or conjunctiva in a nested or buckshot pattern
IHC: (+) EMA (highlights individual vacuoles), CK7 (???), fXIII (in some clones)
- MC eyelid malignancy?
BCC
Endocrine mucin producing sweat gland carcinoma (EMPSGC)
Rare, low grade adenocarcinoma of sweat gland origin often arising on or near the eyelids of older women
- can recur if incompletely excised and may be precursor to mucinous carcinoma, however, no reported cases of mets
- key feature is neuroendocrine expression, elaboration of a myoepithelial layer by immunohistochemistry is helpful to confirm primary cutaneous origin
Micro:
nodular, often multilobulated dermal tumor with solid and cystic areas
- solid areas show cribriform architecture or pseudorosettes
DDx:
- must be distinguished from metastatic adenocarcinoma
- resembles mammary solid papillary carcinoma / endocrine ductal carcinoma with cystic and solid architecture




EMPSGC
EMPSGC CK7
EMPSGC synaptophysin
EMPSGC
1 - 4
<
>
Pleomorphic Dermal Sarcoma (PDS)
- undifferentiated tumor of uncertain histogenesis, typically diagnosed by excluding other possibilities.
- lacks expression of epithelial, melanocytic, vascular, or muscle markers and is thought to represent a spectrum of the same entity as atypical fibroxanthoma. - commonly found in older individuals with chronic UV exposed skin, often associated with UV-dependent cutaneous epithelial malignancies like actinic keratosis and squamous cell carcinoma.
These lesions are often found on the scalp of elderly men and may be ulcerated.
IHC: (+) CD10 (strongly and diffusely expressed in both atypical fibroxanthoma (AFX) and PDS, and it may be the only positive stain
Micro: PDS invades the subcutaneous tissue and/or displays lymphovascular/perineural invasion and necrosis, features that distinguish it from AFX.
- Accordingly, PDS portends a higher risk of aggressive behavior than AFX.
Px: Distant metastasis and local recurrences have been reported, and the primary treatment is complete surgical resection. Depth of infiltration and completeness of excision are significant prognostic factors.
PDS


Melanocytic Lesions
General Rules for Melanocytic Tumors [from LASOP 1-21-2023)
Low power examination
•Symmetry; •Junctional component; •Dermal component; •Pigmentation; •Inflammation
Medium Power examination
•Circumscription; •Growth pattern; •Epidermis: nested vs. single cell;
•Dermis: regular nests vs. irregular nests or confluent
•Maturation: do the melanocytes get smaller deeper in the dermis?
•The best special stain is H&E
•Levels often helpful
•Do not sign out difficult cases when you are tired
•Friday afternoon rule
•Do not be a hero
•Show cases to colleagues
•Get consults when necessary
•Orientation important for accurate diagnosis
•Embedding is more important than cutting
•Beware of fixation artifacts
Ephelis (freckle)
B9 spot on skin exposed to solar rays in those of fair skin and red-heads
- inc risk for skin cancers
Micro: Melanocytes not inc in #; mildly hyperpigmented skin cells in basal layer c normal architecture
Genes: 2/2 variation in melanocortin-1-receptor gene
Lentigo Simplex
Micro: Linear inc in melanocytes at DEJ but no atypia
- bud-like processes from epidermis c "dirty feet"
Lentigo Simplex

Albinism
Pigmented skin disorder, recessive
Number of melanocytes is normal, but the production of melanin is dec bc tyrosinase activity dec
- may be caused by failure of neural crest cell migration during development
Vitiligo
Pigmented skin disorder w irregular areas of complete depigmentation due to a dec # of melanocytes
- assoc w pernicious anemia
*** Vere did the melanocytes GO? ***
Melasma
Pigmented skin disorder w hyperpigmentation usually assoc w pregnancy or OCP use
- the "mask of pregnancy"
- Wood's lamp can highlight the melanin excess in the epidermis
*** inc MELAnin ***
Junctional nevus
Small (<6 mm) symmetrical and well-circumscribed lesion
IHC: Melanocytes appear bland and proliferate in nests and as single cells at the elongated rete ridge tip
- Nests predominate over single cells in the basal layer
- melanophages and pigment incontinence in the papillary dermis
DDx:
- Junctional dysplastic nevus (poorly circumscribed at lateral borders and has nests at the base of the rete ridges)
- Junctional spitz nevus (hyperkeratosis, hypergranulosis and acanthosis, clefts bwt elongated nests and epidermis and large epithelioid melanocytes)
Junctional necus



Junctional nevus (red arrow to junctional [only in epidermis] nests
Junctional nevus

Compound nevus

Compound nevus with atypia
Commonly acquired Melanocytic nevi
Junctional nevi - flat macule
Intradermal nevus - papule with a little pigmentation
- gray cells clustered in nests
- melanocytes will not really be pigmented, usually gray, and can form giant cells (may look scary)
- for nevi in general, melanocytes get smaller the deeper you go into the dermis (maturation) which can look like it is trickling out into the dermis (do not confuse with invasion, as in lots of other lesions)
- melanocytes can have nuclear pseudo inclusion
- "congenital pattern" is that melanocytes surrounds structures like hair follicles, maybe bc the structures formed into the nevus
- melanocytes can be spindly deep down also
Compound nevus - a little bit of both
Maturation in a nevus:
Type A cells - superficially in dermis, epithelioid, square and large
Type B cells - smaller, less cytoplasm, round and no nucleoli (lymphocyte-like)
Type C cells - even smaller than B, spindled, elongated, minimum cytoplasm (neural-like)
Intradermal nevus



Melanocyte with nuclear pseudoinclusion

Maturation in a nevus - this is NOT invasion
A worrying Clark nevus with gray dots and polygons suggestive of lentiginous melanoma


A very typical presentation of a Clark nevus
Clark nevus- pattern of central globules fading at the periphery


Dysplastic (Clarks) Nevus

Compound melanocytic nevus with architectural disorder and shouldering (S), or extension of the junctional component beyond the dermal nests of melanocytes (D). Rete ridges are irregular and distorted with bridging (B) and eosinophilic fibrosis (arrows). Scattered lymphocytic infiltrate is often present (*).
Dysplastic nevus
Large, oval, multiple c irregular pigmented nests and single melanocytes
- central papule c surrounding macule that fades at border
- junctional part goes at least 3 rete pegs past the intradermal part
- end of retes show club-like hyperplasia
- no deep mits or deep pigment in nests
Low grade - atypical just at the periphery (shoulder region?)
- shoulder goes 0.2 cm beyond the edge of visible lesion
High grade - some parts c lots of cytologic atypia
- high-grade lesions can be treated like melanoma in situ
- high-grade lesions may recur and look atypical, but usually the same
Architecturally Disordered Nevus (ADN)
- aka dysplastic nevus, Clark nevus, atypical nevus
Should specify the degree of atypia (mild, moderate, severe)
- those with a severe degree of atypia are more likely to become melanomas
Histo: >5 cm, melanocytic rests at sides and tips of rete ridges, bridging c melanocytic hyperplasia, lamellar / concentric fibroplasia next to nests, no pagetoid involvement of overlying dermis, little halo change, mild to moderate atypia, macronucleoli in proliferating melanocytes, can have holes in melanocyte expression
- difficult to dx if <0.5 cm
- angulated, hyperchromatic atypical nuclei and bridging c nests and neighboring rete pegs and stromal response
- Shouldering: epidermal component extends beyond dermal
- inc numbers of single melanocytes
Lesion looks more malignant as pt ages and the lesion becomes darker
- may just be arbitrary distinctions between this and melanoma
Assoc w CDKN2A: encodes cyclin-dependent kinase inhibitor 2A, which regulates bwt G1/S by binding cyclin-dependent kinase CDK4
~ chr 9p21
Atypical Lentiginous Nevi
May closely resemble lentiginous melanoma
Tx: requires no further tx once excised (vs lentiginous melanoma which needs re-excision c 0.5 cm margins and follow up)
- differentiate them by degree of cytologic atypia and growth confluence
Balloon cell nevus
Nevus in which melanocytes large, pale with foamy or finely vacuolated cytoplasm, but no atypia
- balloon cells caused by progressive vacuolization and destruction of melanosomes
DDx: RCC (metastatic RCC would have rimming of delicate vessels)

Balloon cell nevus

Becker Nevus
Non-cancerous,large, well-demarcated, brown brithmark mostly in males, but also in females with breast hypoplasia and assoc c high localandrogen receptor expression
- can be present at birth but mostly starts at around puberty, usually occurs on shoulder or upper trunk
- often becomes darker and has hypertrichosis and acne can occur in the nevus
- 2/2 overgrowth of the epidermis, melanocytes and hair follicles
- cause is unknown
Micro: inc basal layer pigmentation, mild acanthosis, hyperkeratosis and elongation of rete ridges
- areas c sm muscle hamartoma have more pronounced sm muscle bundles irregularly dispersed in dermis and unrelated to either hair follicles or vascular channels
- does not actually have nevus cells
Tx: can get Ruby laser tx or hair removal

Becker nevus

Cellular blue nevus with dumbbell shape


Blue nevus
Made of type C melanocytes; blue 2/2 Tyndall effect; may come from a non-blue nevus
Gross: small blue-black macule on head and neck
Histo: Elongated, spindly (type C) melanocytes with lots o pigment and melanophages; red sclerotic stroma
- in the interstitium of thick dermal collagen of mid / upper dermis arranged in fascicles or in disarray
- few / rare deep mits, no necrosis, melanovytes dont mature
- "cellular" variant is more closely packed and has little pigment, nuclear enlargement; and is usually seen on the buttocks (
- can be a "malignant" blue nevus if lots of mits, nuclear atypia, or necrosis
IHC: (+) HMB45 (stains GP100 in melanosome)
Loss of BAP1 expression is assoc c melanoma arising from a blue nevus (aka "malignant blue nevus)

Congenital Melanocytic Nevi (CMN)
Evidence of whether congenital melanocytic proliferations are malignant is uncertain
- may have proliferative nodules, but those are not necessarily malignant
- should not dx as "CMN" bc you do not know if it was there at birth, unless you are looking at your own child's CMN...
CMN classified according to projected size into adulthood
- small and medium sized CMN have less than 1% risk of malig transformation
- larger lesions have up to 7.6%
Rarely do CMNs met, and thus the need to excise them is not necessary unless they cover a large portion of the bodies SA
- may grow other types of tumors, but this is very rare
- get hairs growing out of them bc spread along hair follicles
Px: atypical proliferative nodules arising from congenital nevi show whole chromosome gains or losses
CMN


Deep Penetrating Nevus (DPN)
- aka Seab nevus
May be related to CMN
Somewhat large (1-3 cm) variably pigmented plaques (wedge-shaped c longest portion at DE junction) c fascicular arrays of spindle cells, epithelioid elements, dense pigmentation (sometimes), which goes deep
- lots of atypia, mits, necrosis may be a melanoma and not a DPN
Halo nevus
White ring surrounded a pigment papule
Band-like inflam that spreads through the lesion up to the epidermis, which disperses at the base of the lesion
- inflam pattern looks like a "Cocktail Party"... with lymphs and histiocytes hanging out together (in a melanoma, the lymphs act like riot police trying to hold back an angry mob)
- no deep mits or pigment in nests
A: Halo nevus clinical. The halo develops around a preexisting unremarkable compound nevus. B: Halo nevus. A dense infiltrative lymphocytic response blurs the silhouette of the lesional nevus cells in the dermis at scanning magnification. C: Halo nevus. Small lymphocytes are diffusely placed among the dermal nevus cells, which may appear swollen and slightly atypical (“reactive” atypia). Severe or uniform atypia or mitotic activity should suggest the possibility of melanoma. D: Halo nevus. At the periphery of the nevus, the halo is a region where pigment and melanocytes are reduced or absent, and there may be a subtle lymphocytic infiltrate at the dermal–epidermal junction, as here.
https://plasticsurgerykey.com/benign-pigmented-lesions-and-malignant-melanoma/#ic28t2

Nevocellular Nevus
Benign, common mole, aka birthmark
- if >100 present, known as dysplastic nevus syndrome
Spitz Nevus
Approach to Spitz Tumors [1]
•Looks like classic Spitz nevus in child: OK to call Spitz nevus
•Concerning features but not enough to call melanoma: AST
•Any Spitz tumors with atypical features or in adults:
•IHC: Consider p16, BRAF V600E, HMB-45, Ki-67/Melan-A DS, BAP1, PRAME
•If there are worrisome IHC findings, consider molecular testing
Occurs MC on face/scalp, trunk, or extremities in kiddos, up to young adults
- Grossly light red, papulo-nodular, symmetric, no "shoulder", and with distinct borders and small (<1 cm)
- named after Sophie Spitz, a pathologist, who described the histo features of this peculiar nevus in 1948. It presents in 2 forms: either a rapidly growing pink papule or nodule or a black papule or nodule in a young person, typically ages 2-12 yo. Out of that range, begin to suspect melanoma. Dermatoscopically it presents as dot vessels (pink form), clods peripheral, clods central, lines reticular plus clods, and black structureless. A Reed nevus is a variant of a Spitz nevus.
Micro: Symmetric, wedge-shaped, sharp borders (well-circumscribed), pseudoepithiomatous hyperplasia (PEH - acanthosis in adnexal epithelium that can look lilke SCC, sometimes traps elastic fibers), hyperkeratosis and hypergranulosis
- large fusiform / plump epithelioid cells c abundant pink cytoplasm that can look granular / hyaline
- nests DE junction that rain down ("bananas on tree")
- complex epidermal hyperplasia grasps the underlying melanocytic nests
- red nuclear inclusions (Kamino bodies) along BM are made of BM material
- acanthotic epidermis, artificial clefting
- rare mits that are not deep
Subtypes:
Junctional growth pattern c dense pigmentation, called a pigmented spindle cell nevus of Reed
- pigmented spindle cell nevus of Reed is a b9 melanocytic lesion MC in younger pts and has F predominance
-- usually seen on lower limbs (thigh), upper limbs, and trunk
-- on histo, can be junctional or compound, but it is always symmetrical and sharply demarcated
- junctional nests have characteristic pear-shaped config and are made of clusters of plump, spindled cells c elongated vesicular nuclei; and the lesions are heavily pigmented
Compound
Dermal
IHC: (+) S100A6 (diffuse)
- negative MIB-1 in melanocytic nuclei
p16
Spitz
•Diffusely positive
•40-80% of cells
•Positive at all levels
•Nuclei and cytoplasm
•Loss of p16 in Spitz tumor raises concern for spitzoid melanoma
Melanoma
•Variably positive
•0-40% of cells
•Less staining in dermis
•Cytoplasm
Ki-67
Spitz
•Low proliferative rate
•0-10%
•Zonal (upper portion of lesion)
Melanoma
•High proliferative rate
•5-40%
•Present at all levels
Caveats:
1.Overlap
2.Lymphocytes Ki-67 positive (best to do Melan-A/Ki-67 double stain)
3.Thin melanomas
HMB45 and BRAF V600E
HMB45
•Spitz nevi and atypical Spitz tumors show gradient
•Melanomas often diffusely positive
BRAF V600E
•~50-60% of melanomas positive
•Usually in intermittently sun-exposed skin (superficial spreading melanoma)
•True Spitz tumors never positive for BRAF V600E
Genes: 9p21 homozygous deletions have the highest risk to develop advanced local regional dz and even distant mets and death
- 6p25 or 11q13 gains have an intermediate risk c higher likelihood of an adverse event
- 6q23 loss or no copy number aberrations are the lowest risk
DDx: can be a "Spitzoid" melanoma, esp if seen in older pts (which are asymmetric, have deep mits, and nuclear atypia)

Spitz Nevus

Spitz nevus c Kamino bodies

Spitz nevus, shoulder

Spitz nevus



Pigmented spindle cell nevus or Reed
Spitz tumors [1] adapted from WHO


Atypical Spitzoid Lesion
•Traditionally wastebasket term for when you can’t decide (see criteria in the chart above)
•Other choices:
•Spitz tumor of uncertain malignant potential (STUMP)
•Atypical Spitz nevus
•Atypical spitzoid melanocytic proliferation
•Subjective
•Evolving term: Spitz melanocytoma (for Spitz tumors with more than one driver genetic event)
6 features to call atypical Spitzoid nevus:
>1 cm laterally
involvement of underlying subcuatneous adipose tissue
ulcerated
age >10 yo, <1 yo
mits (>6 mm^2)
Tx: Shoud consider re-excision
BAP-1 Inactivated Nevus
(Not truly a Spitz tumor)
Benign behavior
• Distinct histologic features
• Polypoid, mostly intradermal
• Sheets of epithelioid cells with
defined cell borders
• Numerous tumor infiltrating
lymphocytes
Patients with multiple: germline
mutation and increased risk of
cancer
• Uveal melanoma, mesothelioma,
cutaneous melanoma, renal cell
carcinoma, basal cell carcinoma,
hepatocellular carcinoma,
cholangiocarcinoma, meningioma

BAP1 inactivated nevus

Recurrent (Persistent) Nevus
aka pseudomelanoma
Melanocytic prolif that is poorly nested, confluent or irregularly nested with an underlying scar and melanocytic prolif just in that area above the scar
- can be ascary and look like melanoma
- epidermis looks flat
•Present as recurrent pigmented lesion or change in incompletely excised nevus
•Usually in setting of previous shave biopsy or trauma
•Original biopsy may show incomplete or apparently complete removal
•Trauma prone areas
•Lower legs; •Where clothes rub; •Face
Practical Tips
•Architecturally worrisome only over scar
•Bland nuclei (usually)
•Dermal component bland
•History/location
•Absence of history or benign nevus, be careful:
•Consider descriptive diagnosis of ‘atypical melanocytic proliferation over scar, see note’
•Note: In the appropriate clinical context this could represent a recurrent nevus, but a regressed melanocytic lesion or regressed melanoma could be considered.
Recurrent nevus

Nevi during “hormonal states”
•Common nevi in pregnant patients or teenagers may have some atypia and rare mitotic figures
•Still matures with descent
•Low power features resemble conventional nevus

Nevus during hormonal state

Nevi of “special sites”
•Scalp, especially hairline
•Ear/Scalp
•Intertriginous areas
•Genital skin
•Breast
•Ankles
•Acral skin
Common theme to special site nevi:
•Increased architectural disorder
•Odd placement of nests
•Less symmetry
•Some single cell growth pattern
•Some upward migration
•Increased cytologic atypia
Acral Nevus
•Clinical features
•Fairly common: ~5% of Caucasians
•Usually relatively small
•Microscopic features
•Symmetric
•Single cell growth pattern common
•Upward spread of melanocytes
•Tends to spare dermal papillae
•Rare atypical cells in junctional component
•Often poorly circumscribed
•Dermal component bland
•PRAME negative
•Differential diagnosis: acralmelanoma
Acral nevus vs. Acral melanoma [1]
Nevus
•Younger patients
•Small (<1 cm)
•No pleomorphism
•Nuclei less hyperchromatic
•Single cell pattern on rete tips
•Pagetoid spread more central
•Dermal component bland
Melanoma
•Older patients
•Larger (>1 cm)
•Pleomorphism
•Often angulated hyperchromatic nuclei
•Single cell pattern contiguous
•Pagetoid spread throughout
•Dermal component with atypia

Acral nevus

Atypical Genital Nevi
Clinical Features [1]
•Young women (mean age 20s)
•Can occur in children or older adults
•Vulva and anatomic milk line (breasts, axillae, periumbilical, groin)
•Average size 5-6 mm
•Approximately half clinically ‘atypical’
•Labia majora, mons pubis, labia minora, clitoris, perineum
Micro:
Relatively symmetric but with other worrisome features
•Lentiginous and nested junctional component, often with retraction spaces
•Epithelioid melanocytes in junctional component
•Pagetoid spread often present (~20%) but focal
•Atypia: mild (20%), moderate (64%), severe (20%)
•Dermal atypia (39%) but restricted to upper dermis
•Dermal mitotic figures (7%)
•Dermal fibrosis (41%)
•All lesions had maturation
•Large common dermal nevus component in almost half of cases
•Dermal atypia (39%) but restricted to upper dermis
•Dermal mitotic figures (7%)
•Dermal fibrosis (41%)
•All lesions had maturation
•Large common dermal nevus component in almost half of cases
Differential Dx: Vulvar Melanoma
Atypical Genital Nevus (AGN)
•Younger patients
•Symmetric
•Nested
•Pagetoid spread focal
•Maturation
•Marked atypia uncommon
•Absent to rare MFs
Vulvar melanoma
•Postmenopausal
•Asymmetric
•Single cell to irregular nests
•Pagetoid spread prominent
•No maturation
•Marked atypia common
•Dermal MFs
atypical genital nevus


Melanoma in situ on Sun-damaged Skin (Lentigo maligna)
•Subtle on heavily sun damaged skin of head and neck (lentigo maligna type)
•Contiguous proliferation of melanocytes
•Focal nests
•Upward migration usually not prominent
•Atypia usually mild
No dermal nests + solar elastosis = LMM
Poorly nested and confluent melanocytes at DEJ
- loves hair follicles
- melanocytes MUST BE BACK TO BACK
Broad lesion on skin that may have solar keratosis c effaced rete pegs, junctional growth of strange melanocytes (singly and in confluent nests), MNGCs at DEJ, melanocytes not in nests > melanocytes in nests (pleomorphic, unevenly distributed nests), asymmetrical, no clear borders
- extends beyond clinical lesion
- commonly has skip lesions (not good for small bx's - broad shaves are best)
- grows along hair follicles / glands
Differential diagnosis
•Pigmented actinic keratosis
•Solar lentigo
Practical tips
•Any contiguous proliferation of melanocytes or nests worrisome for melanoma in situ
•Extension down follicles
•Junctional dysplastic nevi very rare in heavily sun-damaged skin of elderly patients
•Immunostains can help distinguish pigmented AK from MIS (red chromogen can be helpful)
•HMB45, S100, MiTF, SOX-10, PRAME (beware of pitfalls)
•Beware Melan-A in inflamed skin
Lentigo maligna


Melanoma
Incidence on the rise; ~10k deaths annually
- MCC death from cutaneous neoplasm
Common tumor w high risk of mets; may or may not be assoc c inc sun exposure
Dysplastic nevus (atypical mole) is a precursor lesion
*** ABCDEF: Asymetry, Borders irregular, Colors (multicolored), Diameter (larger [>0.6 cm]), Evolution / Enlargment (and Elevation), Fair skin people ***
Micro: asymmetric, large DEJ nests (>10 cells), pagetoid growth, atypia, mits deep in the tissue
- can also see inflam (lichenoid or chronic), pigment incontinence, cells c whispy brown cytoplasm
- lymphs act like riot police trying to hold back an angry mob (vs the Cocktail Party of a halo nevus)
Margin Assessment (from LASOP 1-21-23)
•Reactive melanocytic hyperplasia common
•Increased number of melanocytes ≠ positive margin
•Positive margin:
•Contiguous proliferation of melanocytes
•Nests
•Extension far down adnexal structures
•Pagetoidspread
•Melanocytic hyperplasia does not increase risk of local recurrence
•Do not overcall, especially on extremities or trunk
DDx: atypical lentiginous melanocytic proliferations, cellular proliferations in congenital nevi, cellular schwannoma, epithelioid histiocytoma, melanocyte prolif around dermal scars, neurothekoma, proliferating scars, "special site" nevi
IHC: (+) S100 (>99.7% [+]), PNL2, Melan-A, HMB45/50 (stains superficial and deep cells, vs nevi which stain only superficial cells), KBA62, MITF, vimentin, high Ki67
- 1% are (+) for pankeratins, GFAP, desmin, NFP
- many are also positive for a variety of CD's
- neg: CKs, CD10, actin, desmin
IHC should be used primarily to distinguish from non-melanocytic cancers, as these are variably positive (S100 may be most specific / sensitive for melanocytic proteins)
ISH may be used to detect cr abnormalities if dx uncertain; but ISH itself is not completely accurate
PRAME Immunohistochemistry [1]
•PReferentiallyexpressed Antigen in Melanoma
•Cancer testis antigen
•To be considered positive: >75% of tumor cells +
PRAME
Melanoma
•All melanoma subtypes: ~80% positive
•88-90% of superficial spreading, acral, nodular, and lentigo maligna melanomas
•75-94% of lentigo maligna melanoma in situ
•Positive in ~90% of metastatic melanoma
•35% of desmoplastic melanomas
Nevi
•86-96% of all nevus types PRAME negative
•When staining present, <50% of cells positive
•75% Spitz PRAME negative, but diffuse staining has been seen
•Nodal nevi PRAME negative
PRAME Caveats
•Not all melanomas are positive; some completely negative
•Nevi can be positive
•90% concordance of PRAME IHC and molecular methods (FISH, CGH)
•10% of the time it does not
•Difficult to interpret in cases between 50-75% positive
•Potentially not as good in Spitz tumors
•Weak staining hard to interpret
•Rare positive melanocytes in sun-damaged skin
•Sensitivity 75%, specificity 99%
Genes: •Genetic landscape complex
•Not driven by translocations or simple activating mutations alone
•Melanoma associated chromosomal aberrations
•Losses of chromosomes 6p, 8p, 9p and 10q
•Gains of 1q, 6p, 7, 8q, 17q, and 20q
Comparative genomic hybridization
•Not widely available
•Takes weeks
•Expensive
•May not be covered by insurance
•Requires relatively high percentage of tumor cells (30-50% of cells assayed)
•Not good for small amounts of tumor or heavily inflamed tumors
FISH limits
•Technically challenging
•Expensive equipment
•Still difficult in thin melanomas
•Limited availability
•Less accurate in ambiguous tumors
•~70%
•Sensitivity 70% in spitzoid melanomas
•Specificity ~80%
•Tetraploidy in Spitz tumors
GEP
•RNA extracted from FFPE tissue
•cDNA
•Quantitative PCR
•23 differentially expressed genes
•PCR
4-probe FISH assay targeting 6p25 (RREB1), Cep6 (centromere 6 / CEN6), and 11q13 (CCND1) can distinguish bwt n9 nevi and unequivocal melanoma c 87% sens and 95% spec
- recently found that probe including 6p25 (RREB1), 11q13 (CCND1), 9p21 (CDKN2A) and 8q24 (C-MYC) had even better accuracy c 94% sens and 98% spec
FISH vs. GEP
•Limitation: based on H&E “gold standard”
•Similar sensitivity and specificity
•At least with validation sets
•Advantages FISH:
•Can look at specific subpopulations
•Better for melanomas arising in nevi
•Better in spitzoid lesions
•Advantages GEP
•Less subjectivity (FISH algorithms are complex)
•No issue with tetraploidy
•May be better on thin lesions
•Advantages GEP
•Less subjectivity (FISH algorithms are complex)
•No issue with tetraploidy
•May be better on thin lesions
FISH and GEP
•Both have potential adjunct role
•Positive results helpful
•Negative/indeterminate results less useful
•Performance on histologically indeterminate lesions is somewhat limited, but may be better than immunohistochemistry
Next generation sequencing
•Advantages
•Can find fusions (Spitz tumors)
•Can find TERT promoter mutations
•Can look at many genes with one assay
•Tumor mutational burden (TMB)
•Disadvantages
•Does not always work on small specimens
•Limited availability
Tx: Wide-excision
- no benefit of LN dissection
- anti-PDI and CDL-1a?
Px: worse px assoc c: vertical growth, lots o mits, ulceration, vessel invasion, satellitosis, max tumor (Breslow) thickness
- can be staged c "Clark level" and "Breslow depth"
- counterintuitively, 75% of melanomas that appear to "regress" on the surface are metastatic (probably have just grown down into the skin and invade [like a falling drop of water...])
- for staging, depth based from base of ulcer or granular layer of epidermis
- inc Lactate Dehydrogenase assoc c worse px [1]
Satellite lesion defined as a nest of melanoma cells (at least 0.05 mm in diameter) separated from the main tumor mass by normal dermis, by a distance of at least 0.3 mm
Staging based on VGP (Vertical Growth Phase): tumors first grow superficially in a circle, and as they do so acquire gene abnormalities that allow them to invade (vertically)
- exception: thin tumors that go deep
Melanoma

Balloon cell melanoma



spijndle cell melanoma


Desmoplastic Malignant Melanoma (DMM)
•Approximately 4% of all melanomas
•Frequent cause of malpractice cases
•Present in 6thto 7thdecades
•Most commonly involve head and neck
•But can be seen anywhere
•More than half clinically amelanotic
•Potential for delayed diagnosis
•Clinically suspected in minority of cases
BE AFRAID!!! Doesn't look like typical melanoma grossly, but like a nodule on sun-exposed areas in the elderly
- is amelanotic, which is why may be confused c other derm probs (inclusion cyst, scar, DF, BCC, nevus)
- may arise from lentiginous melanoma
Histo:
•Hypocellularproliferation of hyperchromatic spindled cells
•Often have packetedarrangement
•Melanin pigment absent to sparse
•Prominent collagenous/desmoplastic stroma
•Perineuralinvasion in 1/3 of cases
•Admixed lymphocytic infiltrate
•Overlying junctional atypical melanocytic proliferation (40-90%)
•May have admixed conventional melanoma
spindly cells in sclerotic stroma (can be confused c NF) with variable nuclear features
- usually invades deep and far (esp if epithelioid [vs fusiform])
- lymphocytic aggregates helpful
DDx: cicatrix (are neater [arranged in parallel and horizontally]), hypopigmented / sclerosed blue nevus, PNSTs, sarcomatoid carcinoma, atypical fibroxanthoma
IHC: (+) S100, SOX10, WT1 (n)
- negative: HMB45, melan-A, tyrosinase, PNL2
-- scars from prior melano excision can also be (+) S100!!! SOX10 may be helpful with this differential (neg in scars)
- kind of goes back to neural crest origin, which is why it only expresses S100 and SOX10
Px:
•Higher rate of local recurrence (10-50%)
•Secondary to infiltrative growth pattern
•Neurotropism increases risk
•Lower rate of lymph node metastasis
•Overall survival better than conventional melanoma if strictly defined
*** SLAM - spindly dermal lesions abutting epidermis ***
Spindled SCC, Leiomyosarcoma, AFX, Melanoma
Desmoplastic melanoma



Lentiginous Melanoma
Proliferate of single and nested melanocytes within the basal layer (bridging?); more likely to be in situ (non-metastatic??)
- single displaced melanocytes seen in upper epidermis as the lesion progresses
2 Types: Can occur acrally (on the palms or soles; thus "acral-lentiginous melanomas") with surface keratinization or just as a simple "lentiginous melanoma" with atrophied epidermis with a good amt of solar damage
Nevoid Melanoma
aka "minimal-deviation" melanoma,
•Clinical features
•May be innocuous
•Verrucous to dome shaped
- look pretty boring on histo: symmetrical, well-circumscribed, don't move up too far past the DEJ, monomorphic cells (like a melanocytic or Spitz nevus)
- cells at base of lesion usually smaller, simulating (falsely) a maturation process
- Subtype of lentiginous and nodular melanomas
Commonly in the LE of older women
Versus nevi, cells in nevoid melanomas are larger, grow in cords, have nucleoli in most cancerous cells, and with mits at the base
- need adequate excision bc these features impossible to tell from punch bx's or shaves
Microscopic features
•Resembles nevus on scanning magnification
•Small epithelioid melanocytes
•Subtle atypia
•Mitotic activity
•May have sheet-like growth and irregular dermal nests
Outcome [1]
•Recurrence rate 50%
•Metastasis 25-50%
•Mortality ≥ 25%
•Likely due to more advanced stage at presentation
•Practical tips
•Examine all nevi at least briefly at high power
•Beware of nevi with sheet-like growth pattern or irregular dermal nests
nevoid melanoma


Nodular Melanoma
Looks like a nodule of atypical melanocytes, and should not have cancerous melanocytes on >3 rete ridges outside (to the left and right) of invasive zone
Superficial Spreading (Pagetoid) Melanoma
MC microscopic subtype
Histo: Lots of atypical melanocytes that move up into the upper layers of the epidermis (and possibly invade downward as well)
** "Buckshot" pattern **
Acral Melanoma
•Clinical Features
•Older patients 7thand 8thdecades
•Rare <30 years of age
•Usually large (1-3 cm)
•Irregularly pigmented
•Foot > hand
•Most common form of melanoma in darker pigmented people
•Microscopic features
•Asymmetric
•May have skip areas
•Single cell growth pattern
•Irregular nests
•Pagetoidspread > than acralnevi
•Hyperchromatic nuclei with haloes
•PRAME positive
•Skip areas frequent
•Biopsies not always diagnostic (especially from lesion edge)
•Consider re-biopsy if clinically suspicious
Acral melanoma


Acral Lentiginous Melanoma
Micro: contiguous proliferation of lentiginous melanocytes with areas of confluent nesting
- rete ridges markedly elongated and pointyd
- melanocytes hyperchromatic and angulated
Acral Lentiginous Melanoma


Spitz Melanoma and Spitzoid Melanoma
Spitz Melanoma
•Reserved for Spitz-like tumors with additional (molecular) features of malignancy
•Needs background genetics of Spitz tumors (e.g. BRAFfusion)
Spitzoid melanoma
•Looks “Spitzy” (epithelioid morphology)
•Other features of conventional melanoma (e.g. BRAF V600E)
Kinase fusions are frequent in Spitz tumors and spitzoid melanomas
Kinase Fusions (~50%)
•Receptor tyrosine kinase translocations
•ROS1
•NTRK1
•ALK
•BRAF
•RET
•Wide range of partners
•Younger patients
•Mutually exclusive with themselves and HRAS
•Chimeric proteins maintain intact 3’ kinase domain
•All activate MAPK/ERK and PI3K/AKT/mTOR pathways
•All can be seen in other types of cancer thyroid, lung, glial
ALK fusions
•10-20% of Spitz nevi and AST have ALKfusion
•1% Spitz melanoma
•Clinical
•Large, polypoid
•Usually extremities of young patients
•Morphology
•Predominantly dermal tumors
•Fascicles of spindled melanocytes
•Wedge shaped to plexiform
•Mild to moderate atypia
•No Kamino bodies
NTRK1Fusions
•Most common in Spitz tumors (versus NTRK2and NTRK3)
•10.7% nevi, 25% AST, 21.2% spitzoid melanomas
•Slightly smaller cells on histology
•Mostly spindled
•Lobulaterosette-like nests
•Exaggerated maturation and TILs
•Strong staining for NTRK1 by IHC
•High sensitivity and specificity
•Weak background staining seen in some other melanocytic lesions without fusions
BRAF fusions
•5% of Spitz tumors
•Higher percentage of Spitz melanoma (up to 24%)
•Morphology
•Often have sheet like growth pattern
•Marked pleomorphism
•BRAF immunohistochemical stains do not stain these tumors
MAP3K8 Fusions
•Striking atypia
•Epithelioid morphology with moderate to severe cytologicatypia
•>50% ulcerated
•No to minimal maturation
•Focal hyperpigmenteddermal clones, giant multinucleated cells
•Deep dermal mitoses
•Dermal stromal reaction
•~50% called Spitzoidmelanoma; frequent p16 inactivation; +/-TERT mutations
•Genomics predict behavior (1 child died of disease thus far)

Spitz tumor

Spitz tumor with ALK fusion


Spitz tumor w NTRK1 fusion

MAP3K8 Fusions


Spitz tumor w BRAF fusion
Metastatic Melanoma
Tumors don't become metastatic until entering VGP in which multiple genes mutated and set to invade
- genes may predict where tumor likely to met to
~1/5 primary melanomas will have mets
- 2/3 of these have LN mtets at time of dx, rest (~6% of all primary melanomas) have visceral mets ab initio
Morphologic subtypes of metastatic melanomas: small cell, rhabdoid, signet ring, "balloon cell", myxoid, spindle cell / pleomorphic, rhabdoid
Tx for mets: Best option for most is resection
- chemo can improve survival a little, but rarely acheives complete remission
-- BRAF and MEK inhibitors may also cause SCC in skin and are expensive
Px: isolated pulmonary mets have strangely good survival; rest of mets are pretty poor
Idiopathic Guttate Hypomelanosis (IGH)
Common, acquired b9 condition in older women, sun-exposed areas
Micro: dec melanin pigment in basal layer of the epidermis and reduction in number of dopa-positive melanocytes
- epidermis usually has some atrophy c flattening of rete pegs
- can have basket-weave hyperkeratosis, or perhaps compact keratosis
IGH

References:
1. LASOP. meeting 1-21-23
